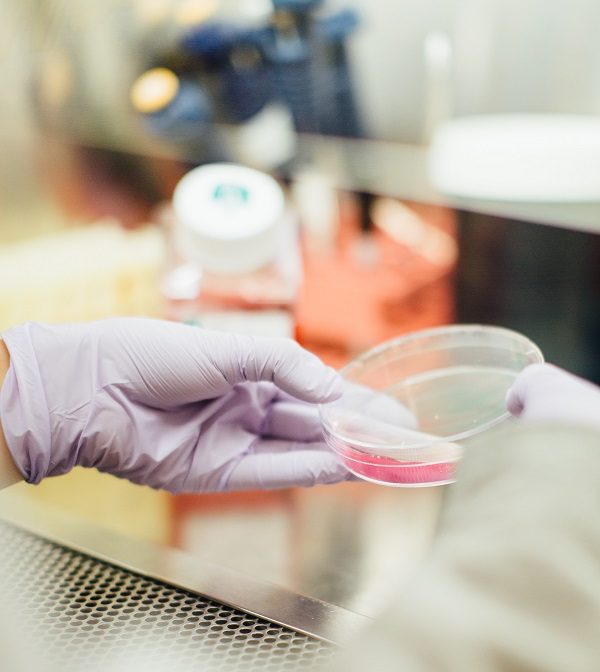

Pediatra aponta a importância da empatia no tratamento de crianças com obesidade
Qualidade de vida da criança com obesidade pode ser pior do que a da criança com câncer
04/03 – Dia Mundial da Obesidade
Julgamento, críticas e rejeição. Se esses tipos de comportamentos com um adulto já são doloridos, imagina uma criança ser tratada assim? A falta de empatia e o bullying são algumas das reações à obesidade infantil, muito frequentes na escola e até mesmo no núcleo familiar.
Uma das características físicas que mais levam ao bullying é a obesidade. Esse tipo de agressão é mais comum entre as meninas e isso tem piorado nos últimos anos. O estudo Getting Worse do início dos anos 2000 mostra que a rejeição da criança obesa piorou 40% desde a década de 60.
A Dra. Denise Lellis, PHD em Pediatria pela Faculdade de Medicina da Universidade de São Paulo (FMUSP), conta que a violência sofrida pela criança obesa é um dos principais motivos que levam as famílias a procurarem ajuda para o tratamento da obesidade.
“Muitos de nós, até mesmo profissionais da área da Saúde, acabamos tendo um comportamento que estigmatiza e maltrata o paciente obeso. Achar que o bullying pode motivar o paciente a procurar ajuda não é verdade. A violência psicológica gera estresse e o estresse faz a criança comer mais. Muitas dessas crianças acabam descontando a sua tristeza na comida, é o comer emocional”, explica Dra. Denise.
Empatia – O posicionamento da Academia Americana de Pediatria de 2018 mostra como é importante que os profissionais envolvidos com obesidade infantil saibam conversar, falar, agir e se comportar frente ao paciente com obesidade.
Uma das referências desse artigo retrata que a qualidade de vida da criança com obesidade pode ser pior do que a qualidade de vida da criança com câncer. “As crianças com câncer têm um apoio muito grande da sociedade, é claro. São vítimas de uma doença grave, não existe julgamento, só empatia, rede de apoio, e a criança é acolhida. Já a criança que está acima do peso recebe o contrário disso”, comenta a pediatra.
Ainda segundo ela, há estudos que mostram que médicos e nutricionistas costumam julgar muito mal o comportamento e até o caráter de crianças e adultos que sofrem de obesidade. “Isso precisa mudar porque muitos desses comportamentos que são julgados como errados, muitas vezes, são causados pelas nossas condutas porque nós, médicos, não conseguimos avaliar se a família está pronta para seguir algumas de nossas orientações”, enfatiza a especialista.
Na Escola – A criança aprende imitando o comportamento do adulto. Se ela frequenta um ambiente onde é comum tirar sarro de alguém, acabará achando que é normal e permitido. Isso também acontece no ambiente escolar.
“As crianças precisam ser tratadas com igualdade de respeito. As escolas precisam parar de pesar e medir as crianças uma na frente das outras e trabalhar a consciência da imagem corporal, o respeito pelas diferenças, ações que mostrem como as crianças e adultos que são julgados podem sofrer, o quanto o bullying pode atrapalhar um tratamento de obesidade, a conscientização de que a obesidade não é uma escolha e pode ser, sim, o resultado de um ambiente onde essa criança vive juntamente com a genética que a acompanha. Tudo isso pode ser explorado pela escola e família. Por mais que precisemos baixar os índices de obesidade, elas primeiro precisam ser vistas como crianças”, orienta Dra. Denise.
Dicas da Especialista – Destacar os talentos dessas crianças para que elas não tenham a autoestima comprometida é algo apontado como muito valioso e que vai impactar para o resto da vida: na inteligência emocional, nas relações socioemocionais.
“Outra dica é sempre falar em saúde e não em perda de peso. Todos precisam ter uma alimentação saudável e não apenas as crianças que estão acima do peso. É o que chamamos de prevenção conjunta: ao mesmo tempo que prevenimos obesidade infantil trabalhamos o transtorno alimentar”, explica Dra. Denise. Além de alimentação saudável, a prática de atividade física é muito importante.
A médica sinaliza que a empatia é uma ferramenta tão importante quanto uma competência técnica no combate à obesidade. Mas há quem não a desenvolva, até mesmo na área da Saúde. “Nesses casos, indicamos que essas pessoas tentem não se pronunciar para não gerar danos e sofrimento emocional. Se for um profissional de Saúde, a indicação é que encaminhe a criança que precisa de tratamento para perda de peso para um outro especialista capacitado e não tente conversar com a família, com a criança e nem fazer cobranças. O recado final que deixo é: criança com obesidade, antes de tudo, é uma criança e precisa ser tratada com carinho, respeito e empatia”, conclui Dra. Denise.
Sobre Dra. Denise Lellis – Doutora em Pediatria pela USP, é membro do departamento de Obesidade Infantil da ABESO (Associação Brasileira para o Estudo da Obesidade e da Síndrome Metabólica), pediatra da Liga de Obesidade Infantil da FMUSP e Coordenadora do curso de Nutrologia Pediátrica para consultório do CAEPP (Centro de Apoio ao Ensino e Pesquisa em Pediatria).
Serviço: